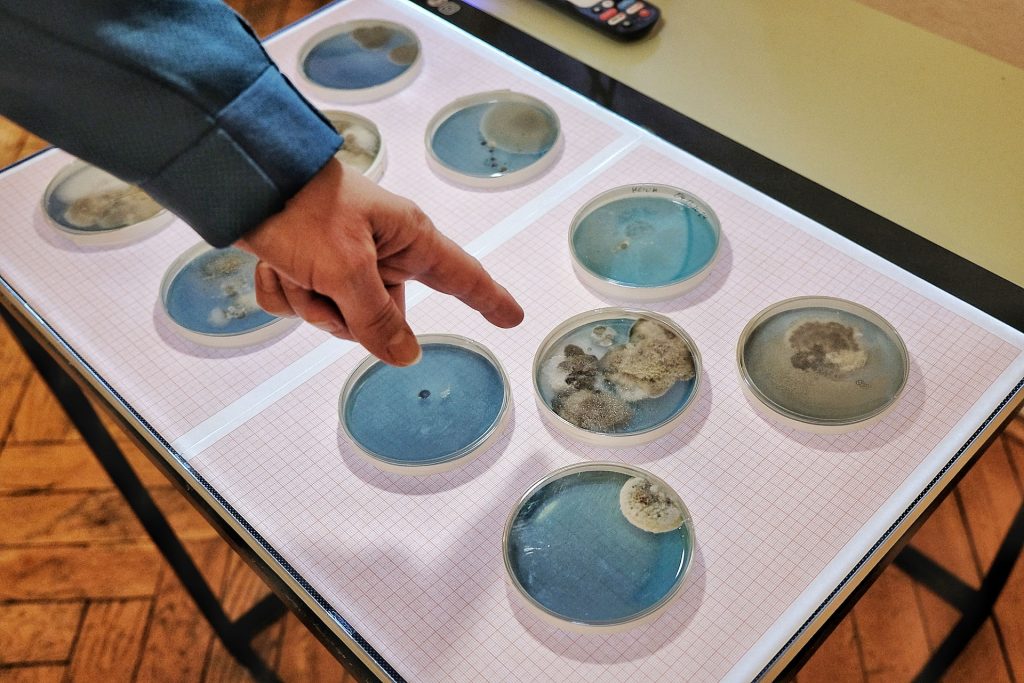
Z cyklu ODCISKI PALCÓW. | Fot. Wit Hadło

„Dno lasu” to wystawa głęboko zakorzeniona w osobistych doświadczeniach i historii regionu. Rzeszowski artysta Bartosz Nalepa dedykuje swoje prace bezimiennym ofiarom II wojny światowej, których ślady wciąż kryją się w leśnym poszyciu.
Spis treści:
W Biurze Wystaw Artystycznych w Rzeszowie w czwartek 8 stycznia miało miejsce bardzo interesujące wydarzenie – wernisaż wystawy „Dno lasu” Bartosza Nalepy otwierającej nowy sezon wystawienniczy 2026 roku.


Rzeszowski artysta nominowany do European Art Preis
Pochodzący z Rzeszowa autor jest absolwentem malarstwa w Akademii Sztuk Pięknych w Krakowie. Studiował w Pracowni Malarstwa Ściennego, na Wydziale Konserwacji i Restauracji Dzieł Sztuki oraz w Pracowni Miedziorytu prof. Stanisława Wejmana.
POLECAMY: Cyrograf z diabłem. „Faust” w Teatrze Wandy Siemaszkowej [ZDJĘCIA]
Znajduje się on w dziewiętnastce malarzy nominowanych przez Galerię Program w Warszawie do polskiej edycji Europen Art Preis. Związany jest z kuratorką Ilona Lee (Magazine) z Nowego Jorku, ale jego prace znajdują się również w ofercie galerii w Krakowie i Barcelonie.
Wystawa „Dno lasu” ukazuje prace plastyczne Bartosza Nalepy wykonane w różnych konwencjach i technikach artystycznych. Obok malarstwa są wielkoformatowe monotypie z olbrzymiego cyklu Flora, realizowanego od czasów pandemii do dnia dzisiejszego, a także wybrane obiekty z cyklów Okamgnienie i Prywatny Gabinet Osobliwości.


Metaforyczna granica pomiędzy życiem a śmiercią
Tytuł wystawy „Dno lasu” pochodzi do inspiracji artysty leśnymi odstępami oraz korytami strumieni i górskich potoków. Podczas takich wypraw artysta szkicuje kadry natury, dokumentuje i zbiera różne artefakty, które wykorzystuje w modelach swoich rzeźb.
ZOBACZ TEŻ: „Ciałokształty – Myślokształty”. Intymna wystawa Beaty Czyżewskiej w Galerii r_z [ZDJĘCIA]
Nalepa kolekcjonuje także najrozmaitsze znalezione okazy do budowania własnych dioram – fragmentów przyrody zatopionych w akwariach lub usytuowanych w gablotach ze zniekształcającymi obraz soczewkami.
– Kilka lat temu, podczas wędrówki z wujkiem przez okoliczny las w pobliżu letniej pracowni, pokazał mi on malutką mogiłę. Podczas II Wojny Światowej pochowano w niej pomordowanych przez Niemców ukrywających się tam Żydów, uciekających z likwidowanych gett, transportów do obozów zagłady czy obozów przymusowej pracy w regionie. A takich masowych, często nieoznaczonych grobów, jest jeszcze wiele w leśnym poszyciu – powiedział podczas wernisażu Bartosz Nalepa.
Robiąc tę wystawę chciałem uczcić pamięć tych ofiar, zanim znaki na Ziemi zupełnie nie przeminą. I to „Dno lasu” pojawia się jako metaforyczna granica pomiędzy życiem a śmiercią
dodał artysta.
I tym właśnie bezimiennym ofiarom dedykuje artysta swoją wystawę symbolicznie usytuowaną w centralnym miejscu dawnej Synagogi Nowej, a obecnie siedziby BWA.

Wernisaż wystawy „Dno lasu” Bartosza Nalepy w rzeszowskim BWA [ZDJĘCIA]
Kuratorką wystawy jest Weronika Gosztyła-Frańczak – niezależna badaczka sztuki. Zdjęcia do katalogu wykonała fotografka Justyna Wijowska-Szpytma.
Wystawa „Dno lasu” będzie czynna do 01.02.2026 r.